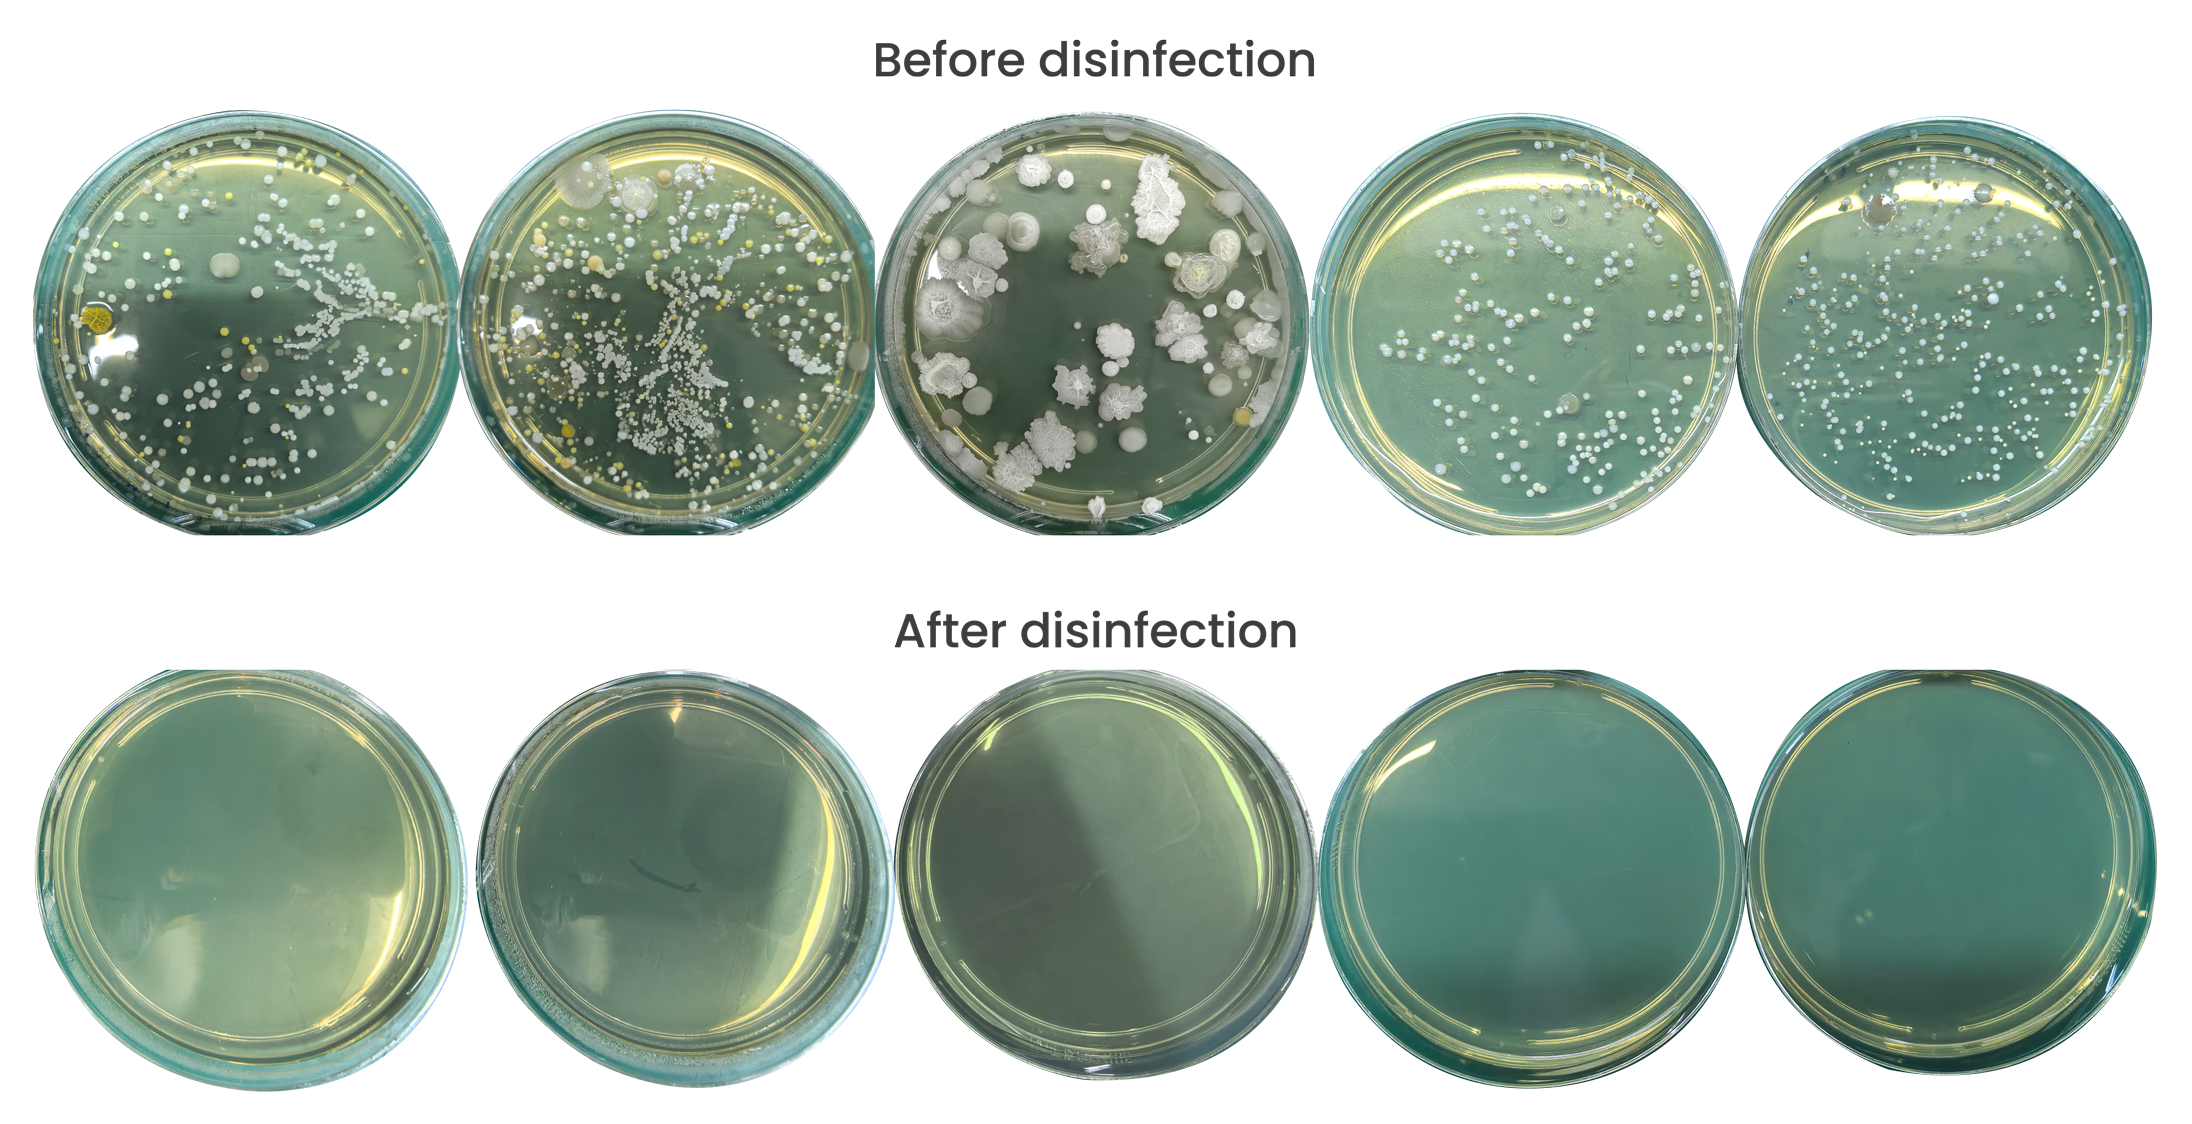
培养皿

Medical UV Disinfection Cabinet for Healthcare Environments
Efficient disinfection solution for high contact items
In hospital environments, high-touch surfaces are critical hubs for pathogen transmission. Keyboards, carts, medical instruments, door handles, call buttons... these seemingly harmless objects can, at any moment, become breeding grounds for multidrug-resistant bacteria and viruses like MRSA, C. diff, and influenza. Traditional chemical wiping methods are prone to human error, missed spots, chemical residue, and issues of microbial resistance.
Unlike traditional methods that rely on chemicals or mercury-based lamps, UVC LEDs offer a clean, efficient, and environmentally friendly alternative.


What is UVC LED Technology?
UVC light, part of the ultraviolet spectrum with wavelengths between 200 and 280 nanometers, has long been known for its germicidal properties. Traditionally, UVC was generated using mercury vapor lamps, but recent advancements have shifted focus to light-emitting diodes (LEDs). UVC LEDs are semiconductor devices that produce UVC light when an electric current passes through them.
This technology is particularly effective for surface disinfection, where it targets microorganisms on objects like countertops, medical equipment, and electronic devices. According to recent reviews, UVC LEDs provide decontamination results comparable to or better than mercury lamps in many scenarios.
How Does UVC LED Surface Disinfection Work?
The disinfection process relies on UVC light's ability to disrupt the DNA and RNA of pathogens, preventing them from reproducing and causing infections. When UVC photons penetrate microbial cells, they create thymine dimers in DNA strands, leading to cell death or inactivation.
For surfaces, devices emit UVC light directly onto the target area. The effectiveness depends on factors like exposure time, distance, intensity (dose), and the type of pathogen. Studies show that UVC can inactivate a wide range of bacteria, viruses, and fungi without leaving residues, unlike chemical disinfectants. For instance, experiments demonstrate reduced bacterial colonies on exposed surfaces with increasing exposure times.

Technological Innovation
Hospital Scenario Solutions
Standardized operation, traceable management, high-efficiency execution

Non-invasive Medical Devices
Electronic & Office Items
Laboratory Equipment

UV Disinfection Cabinet
Support infection control initiatives with ultraviolet (UV-C) light sanitization.
Scientific Data Proves
Through authoritative institution testing and clinical validation, the disinfection effect of the MASSPHOTON surface disinfection cabinet has been fully proven, providing reliable assurance for hospital infection control.

ISO 13485
ISO 9001
CE
SGS
Pilot Cases
Our UV surface disinfection solution enables partner hospitals to achieve a marked reduction in hospital infection rates, offering critical support in creating a safer medical environment.


Customer
Feedback
“Deployed in dermatology and operating rooms, the sterilizer's pure physical UVC LED method effectively reduces cross-infection risks. Its compact design and simple operation integrate seamlessly into existing
workflows. Staff report it is user-friendly with positive feedback."
Keep in touch with us
Get a customized plan from our engineers based on your hospital's unique profile—including departments, patient volume, and risk levels—to streamline your infection control with precision and efficiency.
Mob:+852 2891 8655
E-mail:info@massphoton.com
